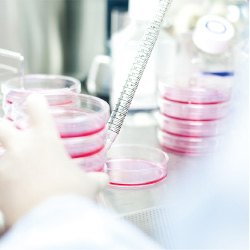

The triangle of “Tradition” , “Wisdom ” and “Innovation”
has created and supported key industries in modern Kyoto.
“Life Sciences”, “Tourism”, “Manufacturing” and “Contents” are the four key industries in modern Kyoto.
“Life Sciences” are represented by iPS cell research in regenerative medicine, while “Tourism” enables visitors to experience ‘good old Japan’ in Kyoto, as one of the largest treasure houses of historic and cultural sites in the world.
In “Manufacturing”, the skills and spirit of craftsmanship that have been nourished in traditional industries have developed state-of-the-art technologies that create our present and future life.
Kyoto has also been the place of origin for the movie industry in Japan, and this culture has developed the rich “Contents” industry ranging from manga and anime to video games.

Life sciences
Center for iPS Cell Research and Application Cell culture chamber
Cell culture chamber
 Human iPS cell
Human iPS cell
 Human neural cell
Human neural cell
 Research experiment
Research experiment

Tourism
Kiyomizu-dera Temple Sado experience
Sado experience
 Rickshaw
Rickshaw
 Foreign Friendly TAXI
Foreign Friendly TAXI
 Machiya
Machiya

Manufacturing
The first unattended railway station systemin the world was developed by a Kyoto-based company
 Sensor Evaluation Kit for Wearable Devices
Sensor Evaluation Kit for Wearable Devices
 Liquid Chromatograph Mass Spectrometer
Liquid Chromatograph Mass Spectrometer
 Fine Ceramic Components
Fine Ceramic Components
 Murata Cheerleaders
Murata Cheerleaders

Contents
Toei Kyoto Studio Park (Drama shooting scene) © 2019 Nintendo
© 2019 Nintendo
 Kyoto International Manga Museum
Kyoto International Manga Museum
 Toei Kyoto Studio Park (film set)
Toei Kyoto Studio Park (film set)
 © Kyoto Prefecture, Mayumaro 2857005
© Kyoto Prefecture, Mayumaro 2857005
Photos provided / with the cooperation of:Center for iPS Cell Research and Application,Kinki District Transport Bureau,Kyoto Convention & Visitors Bureau,KYOCERA Corporation,ROHM Co., Ltd.,Nintendo Co., Ltd.,Murata Manufacturing Co., Ltd.,SHIMADZU CORPORATION,OMRON Corporation,TOEI KYOTO STUDIO Co.,Ltd.,Kyoto International Manga Museum.,Kiyomizu-dera Temple



